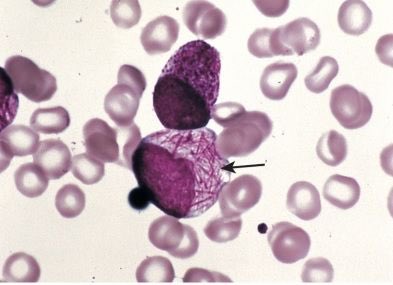

جائزة أفضل تشبيه تروح لعبدالرحمن. 😂
وجائزة اسرع اجابة للمصمم عزوز… 👏🏼
جاري تحميل الاقتراحات...